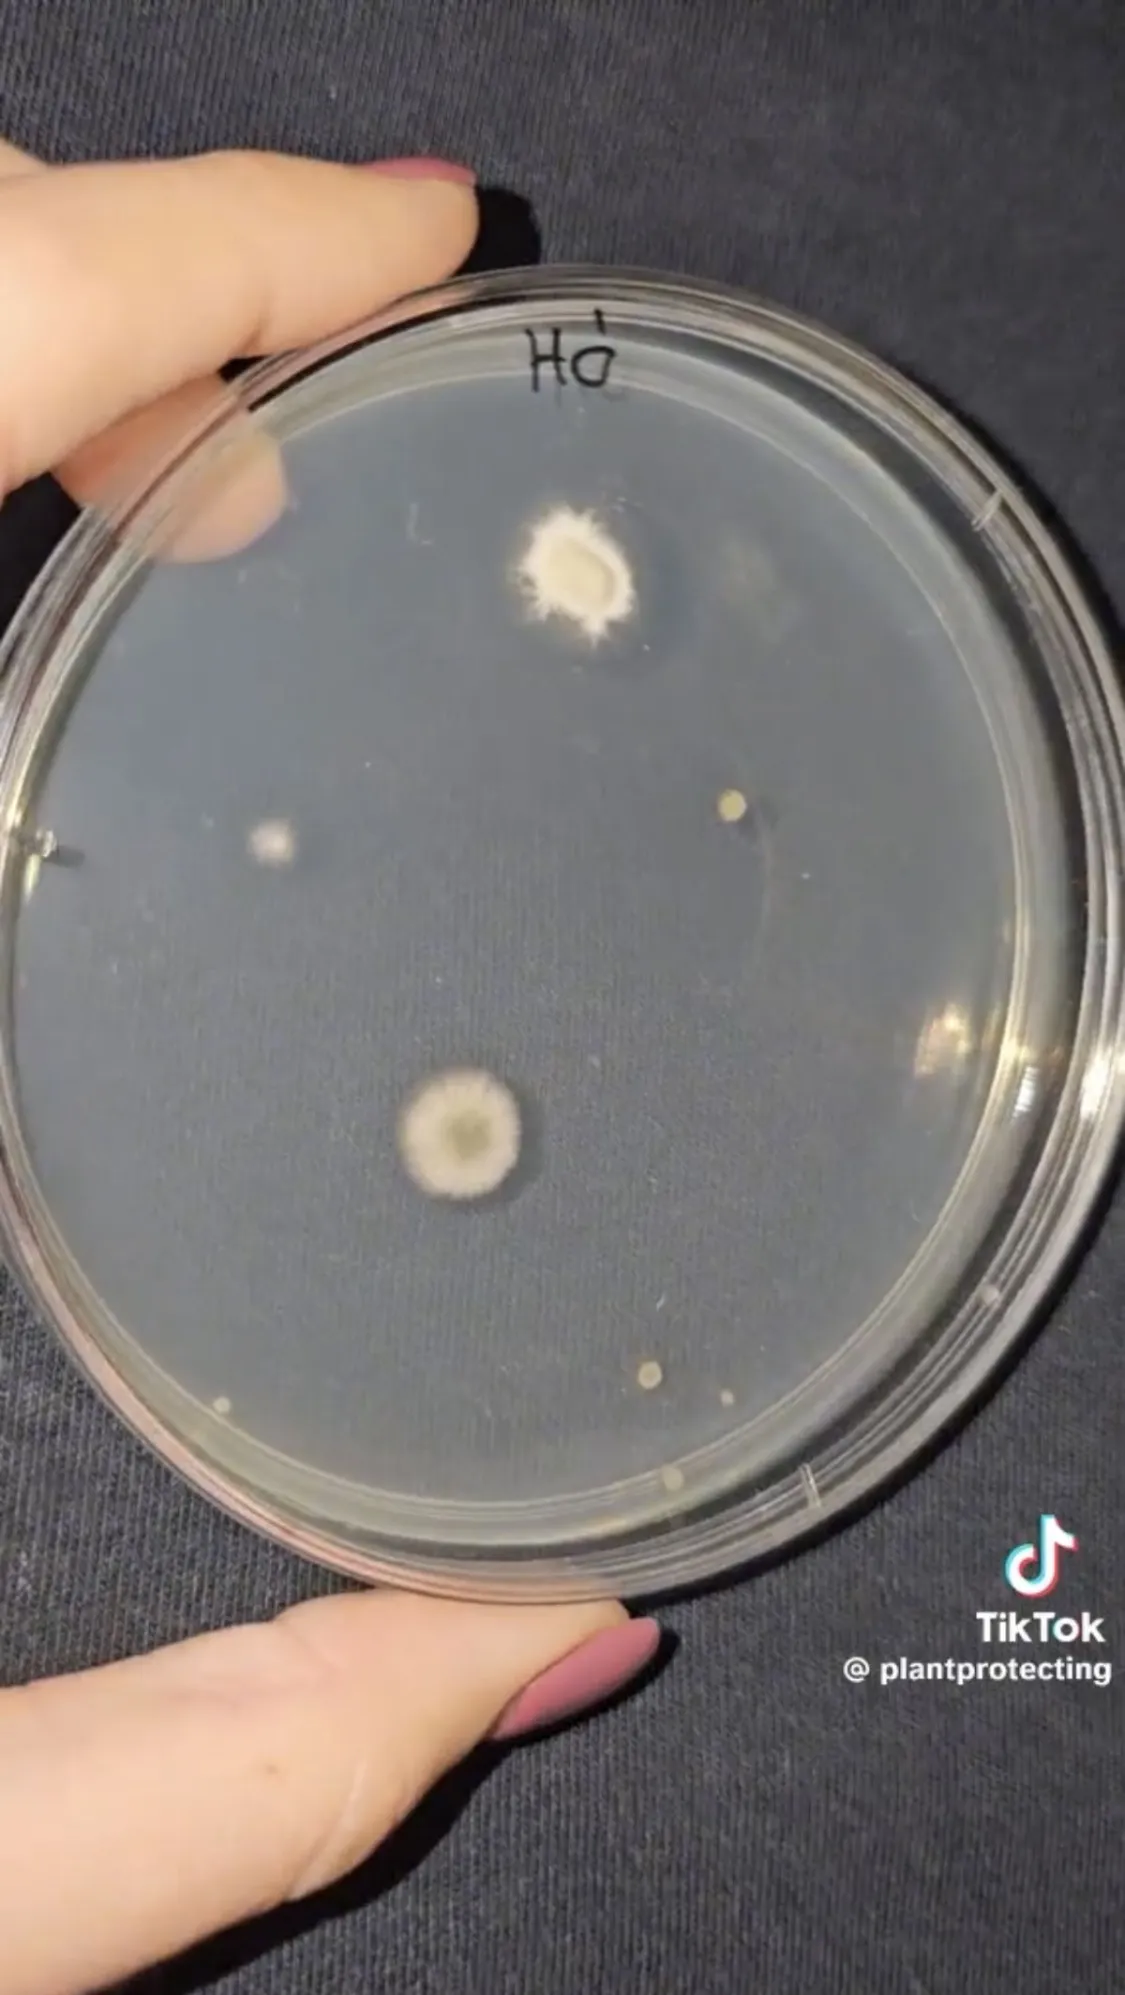

"Sokkal rosszabbra számítottam" – kiderült, mennyire tiszta a frissen hullott hó
Meglepő eredményt tapasztalt Gyuris Rita a hópelyhekkel kapcsolatban. A havas kísérletéről videót is megosztott.
A havas táj elengedhetetlen a karácsonyi hangulathoz. Sajnos azt már tudjuk, hogy valószínűleg idén sem lesz fehér karácsonyunk, de szerencsére csodás havas tájat az ország néhány pontján már láthattunk egy rövid időre. A TikTok kedvenc növényorvosa, Gyuris Rita megragadta az alkalmat és a hóesésben mintát vett a pelyhekről, hogy megnézhesse mennyi baktérium és gomba található rajtuk.
"A mintavétel kifejezetten egyszerű volt"
Rita plantprotecting nevű TikTok-csatornáján előszeretettel tesztel különböző tárgyakat és élelmiszereket, de már azt is megtudhattuk tőle, hogy mennyi baktérium található egy lecsapott szúnyogon.
Nézzük meg, hogy milyen baktériumok, vagy gombák lehetnek a frissen hullott hóban
– kezdte TikTok-videójában Rita, aki egyszerűen csak kitartotta az agar lemezét a hóesésbe . "A mintavétel kifejezetten egyszerű volt."
"Azért a nyelvemmel nem kapnám el a hópehelyeket"
A növényorvos meglepődött az eredményen.
Szerintem ez egy meglepően jó eredmény, én sokkal rosszabbra számítottam, ugyanis baktérium egyáltalán nem nőt fel
– állapította meg a szakember. "Ezek a gombák, melyek a táptalajban szaporodásnak indultak, nagy valószínűséggel a levegőben voltak benne. Azért persze a nyelvemmel nem kapnám el a hópehelyeket, de szerintem ez egy egész jó eredmény."

"Sétáljatok nagyokat"
Végezetül hasznos tanáccsal látta el a követőit: "Sétáljatok nagyokat, legyetek jó levegőn a természetben, ez a legfontosabb!"






